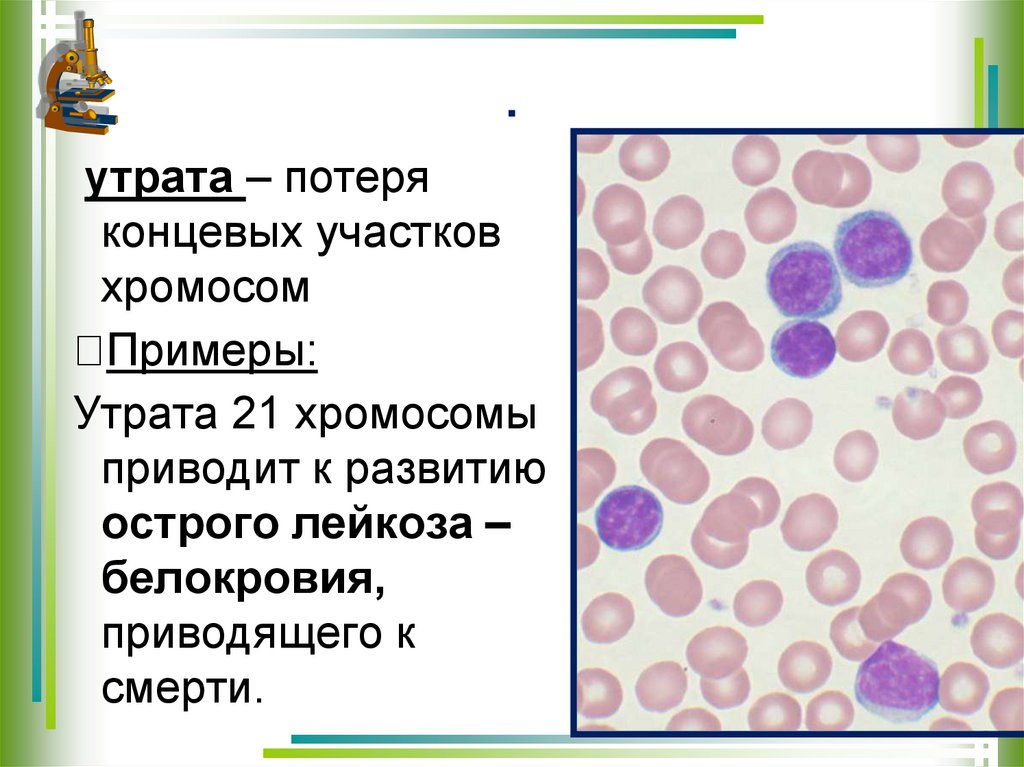

Similar presentations:
Изменчивость Виды изменчивости
1.
ИзменчивостьВиды изменчивости
2.
ИзменчивостьСвойство живых организмов
приобретать в течении жизни новые
признаки.
Выделяют ядерную и внеядерную
(цитоплазматическую – митохондрии,
пластиды) изменчивость.
3.
Различают два вида ядернойизменчивости
Ненаследственная
(фенотипическая,
модификационная)
• фенотип изменяется под
действием факторов
окружающей среды, генотип не
изменяется;
• по наследству не передается
Наследственная
(генотипическая, генетическая)
• изменяется фенотип вследствие
изменения генотипа;
• передается по наследству;
• носит случайный характер;
• непредсказуема, необратима
• является основой разнообразия
живых организмов и главной
причиной эволюционного процесса
4.
Наследственнаяизменчивость
5.
Комбинативная изменчивость это появление новых сочетаний признаковвследствие перекомбинации генов
6.
Комбинативнаяизменчивость
определяет
разнообразие особей и необходима для приспособления вида к
условиям среды. Наличие комбинаций способствует появлению
особей со специфическими признаками, которые используются при
выведении новых сортов растений и пород животных
7.
Мутационная изменчивость.1.Мутации –
качественные или
количественные
изменения ДНК
организмов,
приводящие к
изменениям
генотипа
• Впервые термин "мутация"
ввел в 1901 г. голландский
ботаник Гуго де Фриз
8.
Мутации окраски иформы глаз у
плодовой мушки —
дрозофилы:
1 — дикий тип —
тускло-красные глаза;
мутантные формы:
2 — розовые глаза,
3 — белые глаза,
4 — уменьшенные,
«плосковидные».
9.
Соматические мутации, вызванные у растений ионизирующей радиацией(рентгеновские или гамма-лучи): появление белой окраски в красных
цветках табака (1) и двух сортов львиного зева (2 и 3); на рис. 3 (слева) —
нормальный цветок, справа — мутировавший после облучения.
10.
Мутации - этоизменения наследственного аппарата клетки
Процесс образования мутаций называется мутагенезом,
а факторы, вызывающие мутации, - мутагенными
МУТАГЕНЫ
ПРОДУКТЫ
МЕТАБОЛИЗМА В
ОРГАНИЗМЕ
ФАКТОРЫ ВНЕШНЕЙ
СРЕДЫ
ЭКЗОМУТАГЕНЫ
ФИЗИЧЕСКИЕ
ХИМИЧЕСКИЕ
ЭНДОМУТАГЕНЫ
БИОЛОГИЧЕСКИЕ
11.
• Мутагенные факторы ( мутагены ) факторы, воздействие которых на живыеорганизмы приводит к увеличению числа
мутаций
• а. сильные изменения температуры, атмосферного давления
• б. излучения – рентген, ультрафиолет, альфа, бета и гамма излучение
• в. химические вещества – соли тяжёлых металлов, асбест и др.
• г. курение, алкоголь, наркотические вещества
• д. вирусы, бактерии
12.
Характеристика мутаций⮚ Изменения затрагивают генотип и наследуются
⮚ Изменения носят скачкообразный характер. Не
наблюдается
постепенности
в
изменении
свойств
⮚ Изменения индивидуальны и возникают у
единичных особей в популяции
⮚ Изменения не адекватны условиям среды, т.е.
носят независимый характер, и могут быть
нейтральными, полезными, но чаще всего
являются вредными, могут быть доминантными
и рецессивными
⮚ Мутации могут привести к образованию новых
признаков, популяций или гибели организма
13.
Классификация мутацийI. По причинам
1. Спонтанные – это мутации, которые происходят в
природе без видимых причин. Например: ген гемофилии
2. Индуцированные – это мутации, происходящие при
направленном воздействии мутагенных факторов
II. По мутировавшим клеткам
1. Генеративные – это мутации, возникающие в половых
клетках и передающиеся
размножении
потомкам
2. Соматические – это мутации,
происходящие в соматических клетках и
проявляющиеся только у
самой особи
при
половом
14.
III. По изменению генетическогоматериала
1. Генные - это изменения в пределах одного гена:
а) вставка или выпадение нуклеотида; б) замена одного
нуклеотида на другой. В результате этих мутаций возникает
большинство болезней обмена веществ
Серповидно-клеточная
анемия
Фенилкетонурия
Галактоземия
15.
2. Хромосомные перестройки (аберрации) - этомутации, обусловленные изменением структуры хромосом
а) Внутрихромосомные:
Делеция –
выпадение кусочка хромосомы в
средней части
Дупликация – удвоение участка
хромосомы
б) Межхромосомные:
Инверсия – разрыв участка
хромосомы,
поворот его наего
180°
Транслокация - отрыв участка одной хромосомы
и присоединение
к другой негомологичной
У человека изучена транлокационная форма
болезни Дауна, когда 21-я хромосома
присоединяется к 15-й и вместе с ней передается.
Хромосомные аберрации обнаруживаются цитогенетическими методами
16.
III. Мутационная изменчивость.17.
.утрата – потеря
концевых участков
хромосом
Примеры:
Утрата 21 хромосомы
приводит к развитию
острого лейкоза –
белокровия,
приводящего к
смерти.
18.
Мутационная изменчивость.делеция –
выпадение
средней части
хромосом
• Примеры:
• Синдром
кошачьего крика
(делеция 5
хромосомы)
19.
3. Геномные мутации – это мутации,обусловленные изменением числа хромосом
а) Полиплоидия - это кратное гаплоидному увеличение
числа хромосом: n – гаплоидное число, 2n – диплоид (норма),
3n –триплоид, 4n –татраплоид, 5n – пентаплоид и т.д.
Полиплоидия у человека представляет собой летальную
мутацию. У растений полиплоиды жизнеспособны и
обладают повышенной урожайностью (более крупные
листья, стебли, корнеплоды, плоды, цветки)
б
а
Диплоиды (а) и тетраплоиды (б)
1. Тюльпан
2. Нарцисс 3. Кукуруза
3
а
б
20.
Гетероплоидия (анеуплоидия) это добавление или утрата отдельных хромосомЕсли одна хромосома в паре лишняя – это трисомия, если одной из
пары не хватает – моносомия. В паре нет двух хромосом –
нулесомия (летальная мутация). У человека хорошо изучено
несколько заболеваний, причиной которых является изменение
числа хромосом.
Трисомия по аутосомам:
▪ по 21-й хромосоме – синдром Дауна
▪ по 18-й хромосоме – синдром Эдвардса
▪ по 13-й хромосоме – синдром Патау
Трисомия по половым хромосомам:
▪ XXY – синдром Клайнфельтера (но может быть XXXY, XXYY и др.)
Моносомия по половым хромосомам:
X0 – синдром Шерешевского-Тернера
Геномные мутации обнаруживаются цитогенетическими методами.
Фенотипически проявляются всегда
21.
IV. По исходу для организма1.
Летальные - смертельные. Например: гетероплоидия по
крупным хромосомам (1, 2, 3-й и др.), полиплоидия. Смерть
наступает на ранних этапах индивидуального развития
2.
Полулетальные - снижающие жизнеспособность организма.
Человек, как правило, не доживает до репродуктивного
возраста. Например: синдром Дауна, гемофилия у девочек
3.
Нейтральные
4.
Положительные
-
не
влияющие
на
процессы
жизнедеятельности, продолжительность жизни. Например: цвет
радужной оболочки
-
повышающие
жизнеспособность.
Возникают редко, но имеют большое значение в прогрессивной
эволюции
Механизмы, обеспечивающие устойчивость генетического
материала
а) диплоидный набор хромосом
б) двойная спираль ДНК
в) вырожденный генетический код
г) повторы некоторых генов
д) репарация (восстановление)
молекулы ДНК

biology
biology








